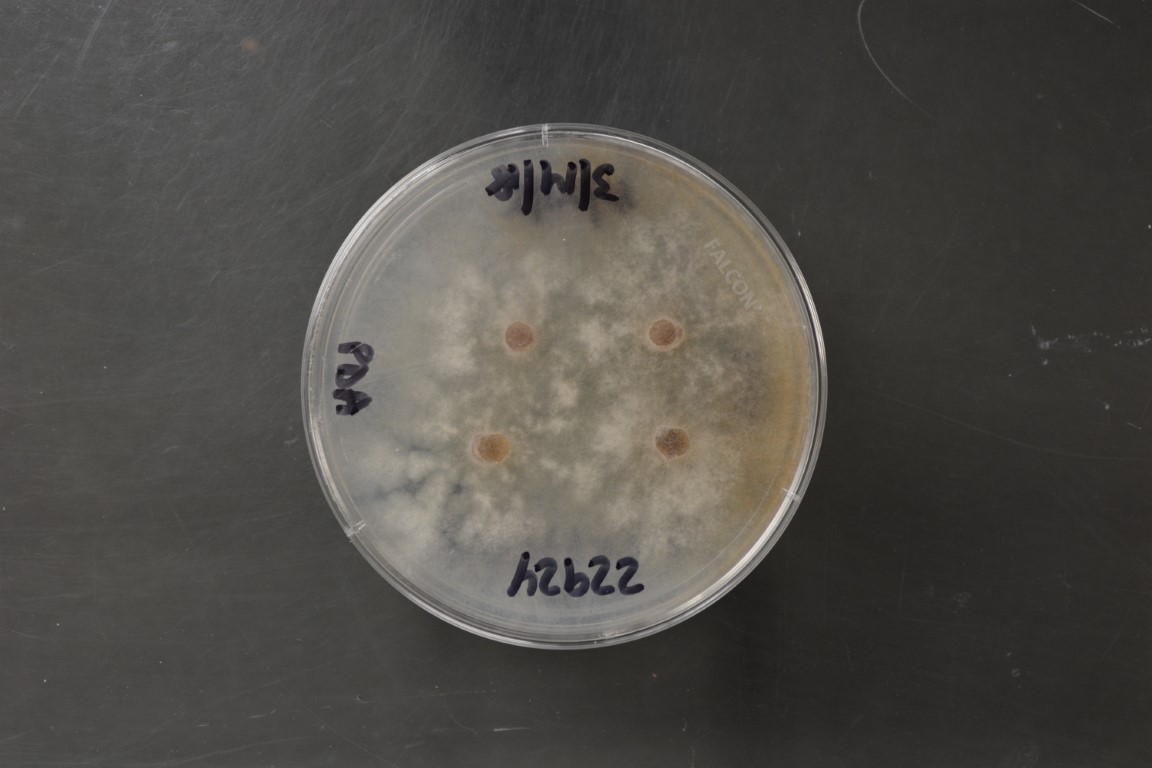

Morchella galilaea
NRRL 22924
Source:K.L.O'Donnell
Substrate location:Hawaii,USA
Genetic info:Du X-H,Zhao Q,O’Donnell K,Rooney AP,Yang ZL.2012.Multigene molecular phylogenetics reveals true morels(Morchella)are especially species-rich in China.Fungal Genet Biol 49:455–469.Du X-H,Zhao Q,Yang ZL,Hansen K,Ta?kin H,Büyükalaca S,Dewsbury D,Moncalvo J-M,Douhan GW,Robert VARG,Crous PW,Rehner SA,Rooney AP,Sink S,O’Donnell K.2012.How well do ITS rDNA sequences differentiate species of true morels(Morchella)?Mycologia 104,1351–1368.O’Donnell K,Rooney AP,Mills GL,Kuo M,Weber NS,Rehner SA.2011.Phylogeny and historical biogeography of true morels(Morchella)reveals an early Cretaceous origin and high continental endemism and provincialism in the Holarctic.Fungal Genet Biol 48:252–265.Richard F,Bellanger JM,Clowez P,Hansen H,O’Donnell K,Urban A,Sauve M,Courtecuisse R,Moreau PA.2015.True morels(Morchella,Pezizales)of Europe and North America:evolutionary relationships inferred from multilocus data and a unified taxonomy.Mycologia 107:359–383.Ta?kin H,Büyükalaca S,Do?an HH,Rehner SA,O’Donnell K.2010.A multigene molecular phylogenetic assessment of true morels(Morchella)in Turkey.Fungal Genet Biol 47:672–682.Ta?kin H,Büyükalaca S,Hansen K,O’Donnell K.2012.Multilocus phylogenetic analysis of true morels(Morchella)reveals high levels of endemics in Turkey relative to other regions of Europe.Mycologia 104:446–461.Ta?kin H,Do?an HH,Büyükalaca S,Clowez P,Moreau P-A,O’Donnell K.2016.Four new morel(Morchella)species in the elata subclade(sect.Distantes)from Turkey.Mycotaxon(in press).Voitk A,Beug MW,O’Donnell K,Burzynski M.2016.Two new species of true morels from Newfoundland and Labrador:cosmopolitan Morchella eohespera and parochial M.laurentiana.Mycologia 108:31–37.
Growth media:Potato Dextrose Agar(number 3)
Optimum growth temperature:25C
Strain images:
NRRL_22924_3.JPG

Comments:Isolated and identified by K.O'Donnell
NRRL22924